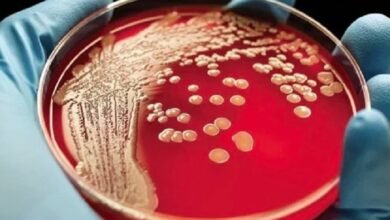
ليست للوقاية بل للعلاج.. خبير روسي يكشف أسرار اللقاح الذكي للقضاء على الخلايا السرطانية

قامت احد الشركات الراعية بتكريم ابطال الأولمبياد الخاص المصري الذين رفعوا اسم مصر عاليا خلال مشاركتهم الناجحة في الألعاب العالمية الشتوية – تورين 2025 وذلك بحضور نخبة من الشخصيات العامة والمسؤولين والداعمين للأولمبياد الخاص.
حفل تكريم أبطال الأولمبياد الخاص
حضر التكريم المهندس أيمن عبد الوهاب الرئيس الإقليمي للأولمبياد الخاص الدولي وأحمد جلال إسماعيل ، والوزير المهندس هاني محمود رئيس الأولمبياد الخاص المصري، واللواء السيد شفيق الأمين العام للأولمبياد الخاص المصري، والفنان الكبير حسين فهمي سفير الأولمبياد الخاص الدولي و محمود يوسف المدير الإقليمي لماجد الفطيم للترفيه مصر ولبنان والدكتور أحمد حسان مدير عام الإدارة العامة لبرامج النشاط الطلابي وخليل محمد رئيس الإدارة المركزية لشئون الإعاقة بوزارة التضامن الاجتماعي، إلى جانب أفراد البعثة المصرية المشاركة في الالعاب.
هؤلاء الأبطال يمثلون نموذجًا حقيقيًا للإرادة
وفي كلمته خلال التكريم، أعرب المهندس أيمن عبد الوهاب الرئيس الاقليمي للاولمبياد الخاص الدولي عن سعادته بالإنجازات التي حققتها البرامج الوطنية للاولمبياد الخاص بأقليم الشرق الارسط وشمال افريقيا ، مشيرا إلي مشاركة ١٧ دولة من المنطقة من أصل 100 دولة حول العالم، ونجح لاعبوا تلك الدول من حصد 50 ميدالية مستحقة، مؤكدًا أن “هؤلاء الأبطال يمثلون نموذجًا حقيقيًا للإرادة والتحدي، ويثبتون للعالم يومًا بعد يوم أن الإعاقة لا تعني العجز، بل تعني مزيدًا من الإصرار والتميز .
وجه عبد الوهاب الشكر لكل الشركاء في وزارات التضامن الإجتماعي والشباب والرياضة والقطاع الخاص لأيمانهم برسالة الأولمبياد الخاص، ومساهمتهم الفاعلة في تحقيق هذا النجاح الإقليمي الكبير
النجاح الذي تحقق في تورين هو ثمرة عمل دؤوب
من جهته، أكد الوزير المهندس هاني محمود رئيس الاولمبياد الخاص المصري أن النجاح الذي تحقق في تورين هو ثمرة عمل دؤوب وتعاون مشترك بين مختلف مؤسسات الدولة والمجتمع المدني لدعم اللاعبين من ذوي الهمم ، مشيرًا إلى أن هذا الإنجاز هو “خطوة جديدة نحو مزيد من النجاحات المستقبلية.
وأكد المهندس هاني محمود أن مصر هذا العام في شاركت في ثلاثة رياضات من الرياضات الشتوية، منها التزلج الألبي و تزلج اختراق الضاحية وهي المرة الأولى التي تخوض فيها مصر هذه المسابقات. وبرغم التحديات، نجح ابطال البعثة المصرية في تحقيق إنجاز غير مسبوق، بحصد ٣ ميداليات متنوعة بالاضافة الي مراكز متقدمة عالميا ، في إنجاز تاريخي أفتخر به جميعا لاول مشاركة لمصر في تلك الرياضات.
حسين فهمي: شرف كبير أن أكون جزءًا من هذا الحدث
كما عبر الفنان الكبير حسين فهمي عن فخره بالدور الذي يلعبه كسفير دولي للأولمبياد الخاص، مضيفًا بأنه شرف كبير أن يكون جزءًا من هذا الحدث وأن يحتفل مع هؤلاء الأبطال الذين يستحقون كل الدعم والتقدير مشيرا الي ان نجاحهم مصدر الهام للجميع .
شهدت الفعالية تفاعلاً حافلاً من الحضور، وسط أجواء احتفالية كرمت فيها البعثة المصرية، التي مثلت مصر في مختلف الرياضات الشتوية، وسط تصفيق لاسر اللاعبين والداعمين.
إنجازات الاولمبياد الخاص
يذكر أن ابطال الاولمبياد الخاص المصري استطاعوا تحقيق انجازات في تلك الالعاب حيث حقق اللاعب محمد النقاش الميدالية الذهبية في سباق 100 متر رجال لتزلج اختراق الضاحية بينما حصلت اللاعبة رضوى أبو سريع على الميدالية البرونزية في سباق 100 متر سيدات لتزلج اختراق الضاحية ، فضلا عن تحقيق انطوان سعد الميدالية البرونزية في سباق التزلج المتعرج علي الثلج ليرتفع إجمالي الميداليات إلى ثلاث ميداليات.
بينما حقق منتخب الجري علي الثلج مراكز متقدمة في اولي تقسيمات المسابقات حيث حقق اللاعب محمود اليهواشي المركز الخامس والمركز السادس بينما حققت ايمان الشافعي مركزين السادس ، بينما حقق فريق التزلج علي الثلج مراكز متقدمة حيث حققت اللاعبة نورهان عثمان مركزين الخامس والسابع بينما حقق انطوان مركز سادس بالاضافة الي الميدالية البرونزية ، وحقق رضوة ابوسريع مركز رابع بالاضافة الي الميدالية البرونزية ، بينما حقق محمد النقاش الميدالية الذهبية.
- للمزيد : تابع العاصمة والناس، وللتواصل الاجتماعي تابعنا علي فيسبوك وتويتر .